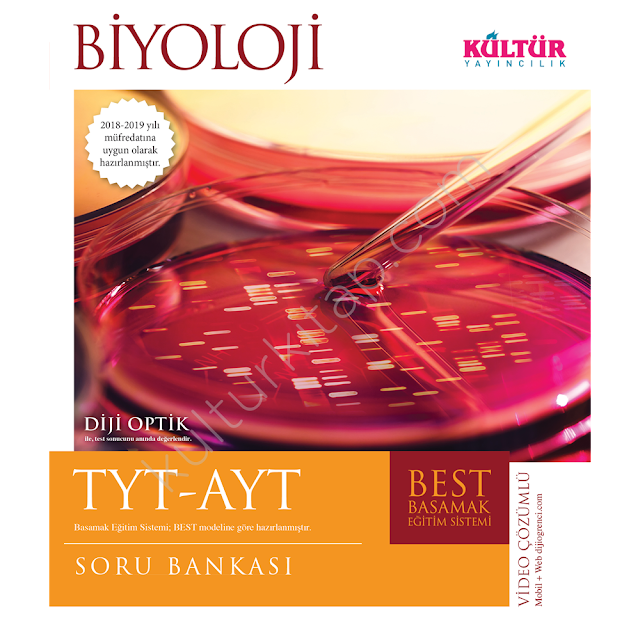

Kültür yayınları biyoloji dersi tyt ve ayt testi için hazırladığı best serisi kültür tyt ayt best biyoloji soru bankası pdf kitabını aşağıdaki linkten pdf olarak indirebilirsin.
Sitemizde bulunan tüm PDF dosyaları yeni müfredat'a tam uyumlu tamamı renkli ve kaliteli yeni basım kitaplardır. Yapmanız gereken aşağıdaki linkten PDF dosyasını normal indirme olarak indirmektir.
PDF Özellikleri
PDF Türü: Renkli ve Yeni Basım
PDF Boyutu: 54.5 Mb
Sitemizde ki PDF dosyaları renkli ve yeni sınav sistemi müfredatına tam uygundur.
UYARI
Sitemizde Paylaşılan Tüm PDF Dosyaları Tamamen Tanıtım Amaçlıdır Kitabı Beğenmeniz Durumunda Orjinalini Almanızı Rica Ederiz.

Yorum Gönder
0 Yorumlar